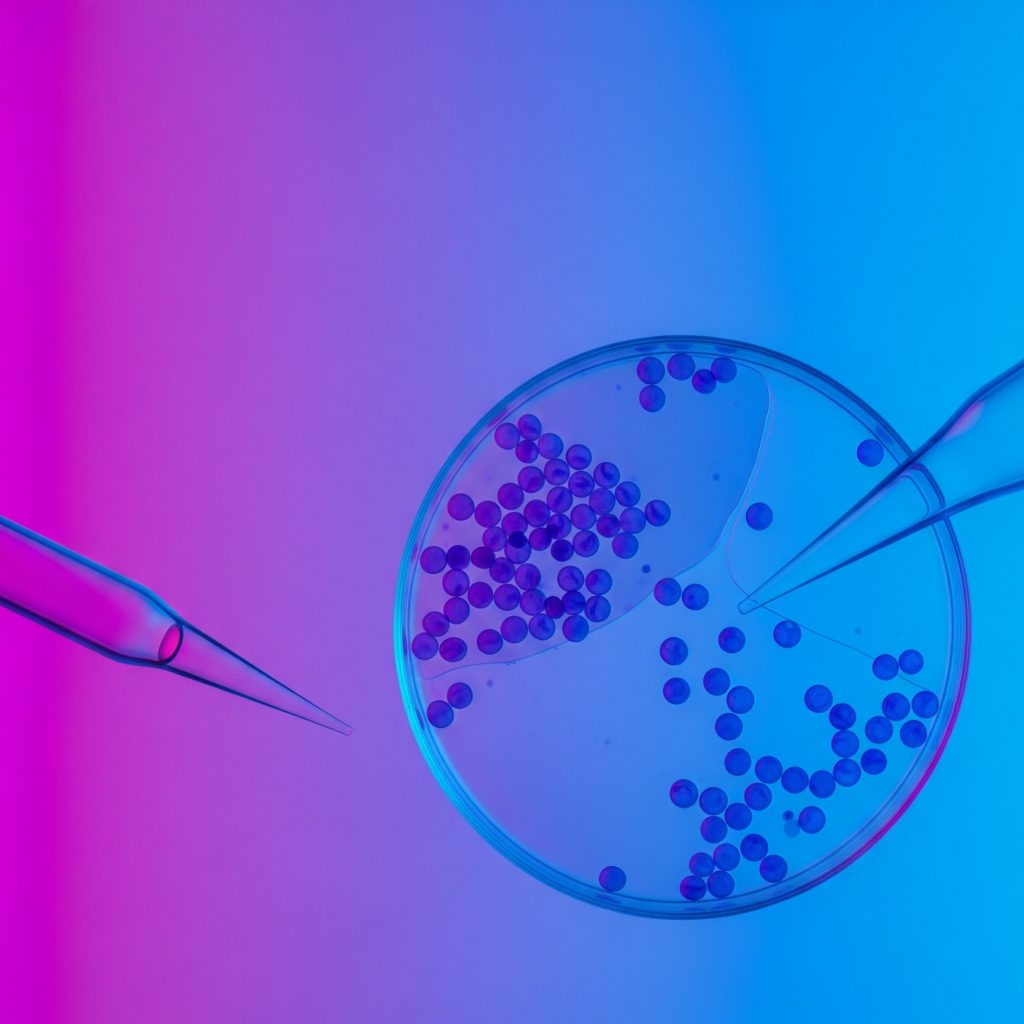
Диагностика хеликобактериоза (деткция антигенов Helicobacter pylori)

Диагностика хеликобактериоза (деткция антигенов Helicobacter pylori)
Биоматериал: кал
Показатель(и): Антигены Helicobacter pylori
Метод(и): Иммуноферментный анализ (ИФА)
Тип контейнера и особенности преаналитики: Стерильный контейнер для кала с ложечкой
Когда назначается
Диагностика хеликобактериоза и ассоциированных с ним заболеваний.
Подготовка к анализу
Специальной подготовки не требуется. Исследование проводится натощак (не принимать пищу 3 часа до исследования, можно пить воду).